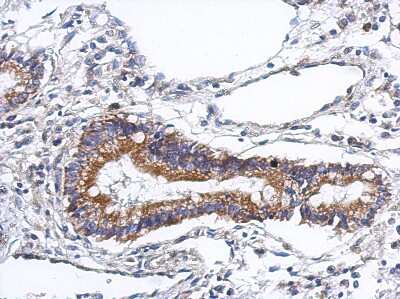

Podocan Antibody - BSA Free
Novus Biologicals, part of Bio-Techne | Catalog # NBP2-19881

Key Product Details
Species Reactivity
Validated:
Human
Predicted:
Bovine (92%), Mouse (95%). Backed by our 100% Guarantee.
Applications
Immunohistochemistry, Immunohistochemistry-Paraffin, Western Blot
Label
Unconjugated
Antibody Source
Polyclonal Rabbit IgG
Format
BSA Free
Concentration
Concentrations vary lot to lot. See vial label for concentration. If unlisted please contact technical services.
Product Specifications
Immunogen
Recombinant protein encompassing a sequence within the center region of human Podocan. The exact sequence is proprietary.
Localization
Secreted; extracellular space; extracellular matrix
Clonality
Polyclonal
Host
Rabbit
Isotype
IgG
Theoretical MW
69 kDa.
Disclaimer note: The observed molecular weight of the protein may vary from the listed predicted molecular weight due to post translational modifications, post translation cleavages, relative charges, and other experimental factors.
Disclaimer note: The observed molecular weight of the protein may vary from the listed predicted molecular weight due to post translational modifications, post translation cleavages, relative charges, and other experimental factors.
Scientific Data Images for Podocan Antibody - BSA Free
Western Blot: Podocan Antibody [NBP2-19881]
Western Blot: Podocan Antibody [NBP2-19881] - Sample (30 ug of whole cell lysate) A: 293T 7. 5% SDS PAGE gel, diluted at 1:2000.Human gastric cancer, using PODN antibody at 1:500 dilution. Antigen Retrieval: Trilogy™ (EDTA based, pH 8.0) buffer, 15min.
Immunohistochemistry-Paraffin: Podocan Antibody [NBP2-19881] - Human gastric cancer, using PODN antibody at 1:500 dilution. Antigen Retrieval: Trilogy™ (EDTA based, pH 8.0) buffer, 15min.Applications for Podocan Antibody - BSA Free
Application
Recommended Usage
Immunohistochemistry
1:100-1:1000
Immunohistochemistry-Paraffin
1:100-1:1000
Western Blot
1:500-1:3000
Formulation, Preparation, and Storage
Purification
Antigen Affinity-purified
Formulation
0.1M Tris, 0.1M Glycine, 20% Glycerol
Format
BSA Free
Preservative
0.01% Thimerosal
Concentration
Concentrations vary lot to lot. See vial label for concentration. If unlisted please contact technical services.
Shipping
The product is shipped with polar packs. Upon receipt, store it immediately at the temperature recommended below.
Stability & Storage
Aliquot and store at -20C or -80C. Avoid freeze-thaw cycles.
Background: Podocan
Alternate Names
PCAN, PODN, SLRR5A
Gene Symbol
PODN
Additional Podocan Products
Product Documents for Podocan Antibody - BSA Free
Product Specific Notices for Podocan Antibody - BSA Free
This product is for research use only and is not approved for use in humans or in clinical diagnosis. Primary Antibodies are guaranteed for 1 year from date of receipt.
Loading...
Loading...
Loading...
Loading...
⚠ WARNING: This product can expose you to chemicals including mercury, which is known to the State of California to cause reproductive toxicity with developmental effects. For more information go to www.P65Warnings.ca.gov.
![Western Blot: Podocan Antibody [NBP2-19881] Western Blot: Podocan Antibody [NBP2-19881]](https://resources.bio-techne.com/images/products/Podocan-Antibody-Western-Blot-NBP2-19881-img0001.jpg)